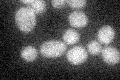
YBR088C
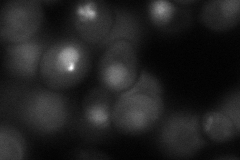
YBR088C

View description
Proliferating cell nuclear antigen (PCNA), functions as the sliding clamp for DNA polymerase delta; may function as a docking site for other proteins required for mitotic and meiotic chromosomal DNA replication and for DNA repair
Localization:
Intensity:
Fold change:
Significance:
-
C’ GFP library in SD
below threshold16.29 -
N' NOP1pr-GFP in SD

punctate,nucleus195.007 -
N' TEF2pr-mCherry in SD

punctate,nucleus272.484 -
N' NATIVEpr-GFP in SD

punctate,nucleus120.457 -
N' TEF2pr-VC and Cyto-VN in SD
punctate,nucleus69.4493 -
C’ GFP library in SD+DTT

cytosol16.51.01No -
C’ GFP library in SD+H2O2

cytosol17.981.1No -
C’ GFP library in Starvation Media

cytosol13.860.85No -
C’ GFP library on the background of Pup2-DaMP

below threshold -
C’ GFP library on the background of CCT mutant

below threshold19.09541.1709No
